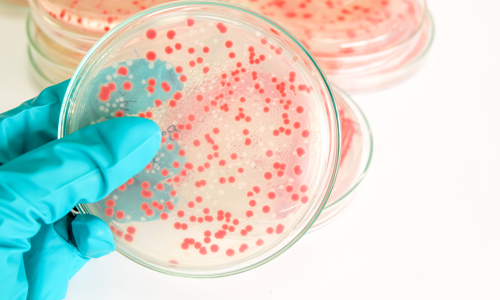

Dr Lena Ciric, an Associate Professor at University College London (UCL), was awarded a HIS Major Research Grant in 2019 to support a PhD studentship for Sam Watkin. The title of the research project awarded is ‘Developing hospital surface sampling protocols for better IP&C’.
In this blog we talk to Lena and Sam about their exciting work and their experiences of their HIS funded research grant.
Increasing levels of evidence have demonstrated the role environmental touch surfaces play in the persistence and transmission of pathogens associated with hospital acquired infection. Such surfaces are rarely monitored for microbial contamination outside of outbreak events, with little known about the microbial communities present on surfaces in the clinical setting. Identifying trends in these communities will allow for more evidence-based environmental infection control interventions.
This study investigates microbial communities routinely present on environmental touch surfaces using methodologies readily available to infection control teams, aiming to identify trends in surface microbial contamination. Microbial contamination of surfaces within the hospital setting is diverse, with large variation in microbial loading and populations.
The trends we have identified from this project suggest distinct patterns for microbial loading and species presence on sites of different activities, types and user groups. Identifying trends such as these builds our understanding of what microbes can inhabit environmental touch surfaces in the clinical setting and builds information to support targeted infection control interventions.

Lena: Myself and my co-investigators had been talking about putting together surface sampling protocols for some time, but felt there was still some evidence we needed to collect before we were able to do this. We thought addressing this through a PhD studentship would work really well – we would train a cross-disciplinary infection control expert and have a clear and effective output, the sampling protocol, that could be disseminated to Infection Prevention Control (IPC) teams.

Lena: The grant has allowed me to interact better with HIS and the IPC community. This has been invaluable as I feel there is no point in carrying out this research without input from teams working in hospitals or producing useful outputs for them.
Sam: The HIS-funded studentship has allowed me to develop an understanding of many different aspects of IPC, the challenges faced and how these can be approached. It has put me in contact with experts across the field of IPC across sectors and industries. I feel the grant has really launched my career in IPC research and given me a wide range of tools to progress.
Lena: Not yet an achievement, but I am really proud of the fact that the project will produce something useful to the IPC community, rather than just academic publications.
Sam: My proudest moment so far has been presenting a research poster at ECCMID 2022 in Lisbon. The opportunity to showcase research I had been a part of at an international forum and discuss my project with a wide variety of healthcare and microbiology professionals was very enjoyable. I’m looking forward to being able to present at more events in the future.

Lena: Grant writing is a labour-intensive process and involves a lot of effort. By its nature, it may be unsuccessful… this is always a gamble, but it certainly paid off on this occasion. It was really useful to receive the reviewers’ comments from HIS and have the opportunity to respond to these and take the feedback into account.

Lena: The grant has funded the fees, stipend, research and travel (e.g. conferences) costs for a three-year project. This means that we have a person to spend a whole three years gathering data, analysing it and writing this up for both publication and for the IPC community. I feel this is excellent value for the award.
Sam: Having my PhD studentship supported by HIS has given me many opportunities to further my knowledge in the field of healthcare associated infection through the invaluable training and sessions organised by the society. I feel that using the grant to fund PhD studentships will greatly help develop research in IPC and is a good way of introducing early-career researchers into this field.